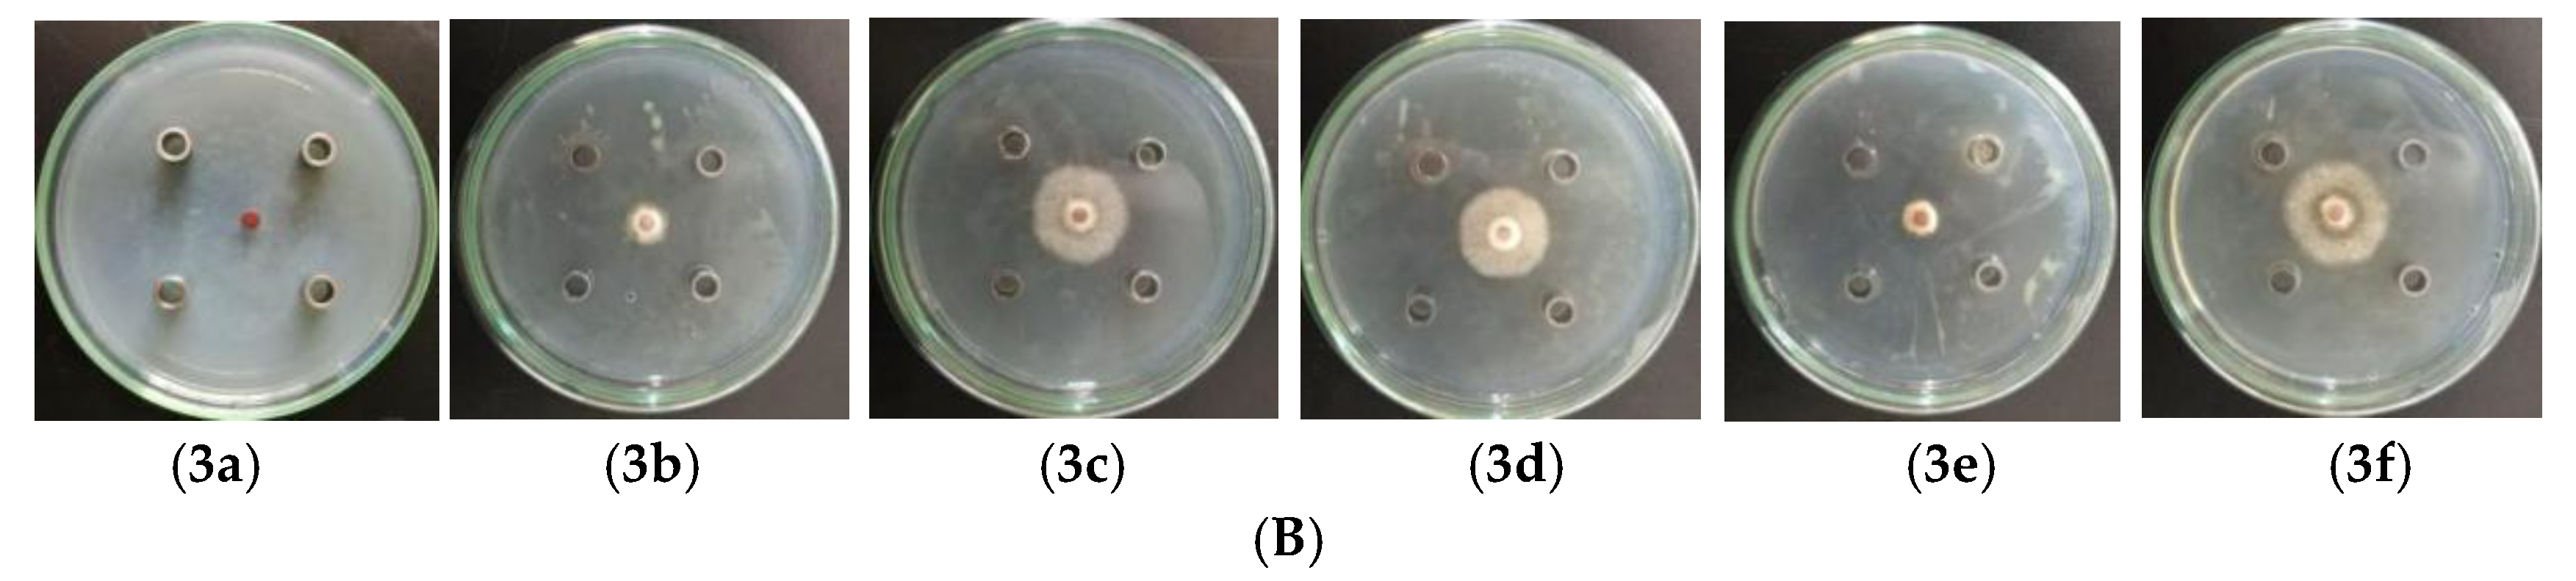
Molecules 23 01021 g001b Molecules 23 01021 g001b

Effects of Essential Oils from Zingiberaceae Plants on Root-Rot Disease of Panax notoginseng
Abstract
1. Introduction
2. Results
2.1. Inhibition of EOs from Zingiberaceae
2.2. Determination of IC50 Values
2.3. GC/MS Analysis of EOs
2.4. The Inhibitory Effects of EO, Camphene, and Eucalyptol from A. tsao-ko
2.5. Antifungal Properties of Linalool and Caryophyllene of EO from A. officinarum
2.6. Useful to Mix “Natural” and “Chemical” Fungicides
3. Discussion
4. Materials and Methods
4.1. Preparation of EOs
4.2. Fungal Strains
4.3. Antifungal Determination of EOs by the Oxford Cup Method
4.4. IC50 Determination of EOs
4.5. GC/MS Analysis of EOs
4.6. Antifungal Determination of EOs and Compounds from EOs
4.7. Synergism of A. tsao-ko EO and Hymexazol against F. oxysporum
4.8. Statistical Analysis
Supplementary Materials
Author Contributions
Funding
Conflicts of Interest
References
- Wang, Y.; Chu, Y.; Li, W.; Ma, X.H.; Wei, Z.P. Advances in study on saponins in Panax notoginseng and their pharmacological activities. Chin. Tradit. Herb Drugs 2015, 46, 1381–1392. [Google Scholar] [CrossRef]
- Miao, Z.Q.; Li, S.D.; Liu, X.Z.; Hen, Y.J.; Li, Y.H.; Wang, Y.; Guo, R.J.; Xia, Z.Y.; Zhang, K.Q. The causal microorganisms of Panax notoginseng root-rot disease. Sci. Agric. Sin. 2006, 39, 1371–1378. [Google Scholar]
- Liu, S.Q.; Zhang, Y.; Liao, X.L.; Bai, L.Y. Resarch status and application prospects of botanical pesticides in china. Hunan Agric. Sci. 2016, 2, 115–119. [Google Scholar]
- Ma, L.H.; Qin, W.D. Study on the antioxidant and monnosaccharide composition of Zingiber officinale Roscoe polysaccharide. China Food Addit. 2010, 31, 113–118. [Google Scholar]
- Xia, D.Z.; Li, J.R.; Liu, J.E.; Wang, H.M.; Ren, Q.Y. The ultrasonic extraction and antioxidant effects of total flavonoids from Alpinia officinarum Hance in vitro. J. Chin. Inst. Food Sci. Technol. 2009, 9, 63–69. [Google Scholar]
- Dixon, R.A. Natural products and plant disease resistance. Nature 2001, 411, 843–847. [Google Scholar] [CrossRef] [PubMed]
- Huang, S.J.; Yin, A.W.; Luo, Z.Y.; Zhou, H.M. Study on the bacteriostasis and antioxidation of Alpinia officinarum Hance volatile oil. Sci. Technol. Food Ind. 2015, 36, 112–115. [Google Scholar] [CrossRef]
- Gui, S.H.; Jiang, D.X.; Yuan, J. Study on antifungal action of volatile oil from pericarpium zanthoxyli and rhizoma alpinae officinarum in vitro. Chin. J. Inf. Tradit. Chin. Med. 2005, 12, 21–22. [Google Scholar]
- Han, L.; Wang, K.T.; Zhao, D.; Tang, H.L.; Liu, X.; Han, Q.L. Chemical composition, antioxidant and antibacterial activities of the essential oil from Amomum tsao-ko. Sci. Technol. Food Ind. 2013, 34, 152–155. [Google Scholar] [CrossRef]
- Yang, Y.; Yue, Y.; Runwei, Y.; Guolin, Z. Cytotoxic, apoptotic and antioxidant activity of the essential oil of Amomum tsao-ko. Bioresour. Technol. 2010, 101, 4205–4211. [Google Scholar] [CrossRef] [PubMed]
- Chen, Y.J.; Wang, Y.; Wang, Q.F.; Ma, C.S.; Li, S.D.; Wu, Z.C.; Li, Y.H. Studies on prevention and control of root rot disease of Panax Notoginseng. Application of seed dressing (Seedling) with compound agent and soil fumigation. China J. Chin. Mater. Med. 2008, 33, 1329–1331. [Google Scholar]
- Peng, G.X.; Guo, H.B.; Zhao, H.G.; Jiao, J.; Deyholos, M.K.; Yan, X.J.; Liu, Y.; Liang, Z.S. Optimal fertilizer application for Panax notoginseng and effect of soil water on root rot disease and saponin contents. J. Ginseng Res. 2016, 40, 38–46. [Google Scholar] [CrossRef]
- Turco, E.; Vizzuso, C.; Franceschini, S.; Ragazzi, A.; Stefanini, F.M. The in vitro effect of gossypol and its interaction with salts on conidial germination and viability of Fusarium oxysporum sp. vasinfectum isolates. J. Appl. Microbiol. 2007, 103, 2370–2381. [Google Scholar] [CrossRef] [PubMed]
- El-Abyad, M.S.; Hindrof, H.; Rizk, M.A. Impact of salinity stress on soil-borne fungi of sugarbeet: II. Growth activities in vitro. Plant. Soil 1988, 110, 33–37. [Google Scholar] [CrossRef]
- Chen, J.L.; Sun, S.Z.; Miao, C.P.; Wu, K.; Chen, Y.W.; Xu, L.H.; Guan, H.L.; Zhao, L.X. Endophytic Trichoderma gamsii YIM PH30019: A promising biocontrol agent with hyperosmolar, mycoparasitism, and antagonistic activities of induced volatile organic compounds on root-rot pathogenic fungi of Panax notoginseng. J. Ginseng Res. 2016, 40, 315–324. [Google Scholar] [CrossRef] [PubMed]
- Kland, M.J. Chapter 8-teratogenicity of pesticides and other environment pollutants. Stud. Environ. Sci. 1988, 31, 315–463. [Google Scholar] [CrossRef]
- Santana, M.B.; Rodrigues, K.J.A.; Durán, R.; Alfonso, M.; Vidal, L.; Campos, F.; De Oliveira, I.M.; Faro, L.R.F. Evaluation of the effects and mechanisms of action of flutriafol, a triazole fungicide, on striatal dopamine release by using in vivo microdialysis in freely moving rats. Ecotoxicol. Environ. Saf. 2009, 72, 1565–1571. [Google Scholar] [CrossRef] [PubMed]
- Hassan, N.; Elsharkawy, M.M.; Shimizu, M.; Hyakumachi, M. Control of root rot and wilt diseases of Roselle under field conditions. Mycobiology 2014, 42, 376–384. [Google Scholar] [CrossRef] [PubMed][Green Version]
- Wang, Y.; You, C.X.; Wang, C.F.; Yang, K.; Chen, R.; Zhang, W.J.; Du, S.S.; Geng, Z.F.; Deng, Z.W. Chemical constituents and insecticidal activities of the essential oil from Amomum tsaoko against two stored-product insects. J. Oleo. Sci. 2014, 63, 1019–1026. [Google Scholar] [CrossRef] [PubMed]
- Dayal, R.; Singh, A.; Ojha, R.P.; Mishra, K.P. Possible therapeutic potential of Helicteres isora (L.) and it’s mechanism of action in diseases. J. Med. Plants Stud. 2015, 3, 95–100. [Google Scholar]
- Zhang, J.H.; Li, M.; Zhang, B.; Ma, T.Z.; Chen, X.; Han, S.Y. Comparison of antimicrobial activity of eight monomer polyphenols to wine microorganisms. Food Ferment Ind. 2016, 42, 101–106. [Google Scholar] [CrossRef]
- Ud-Daula, A.S.; Demirci, F.; Salim, K.A.; Demirci, B.; Lim, L.B.; Baser, K.H.C.; Ahmad, N. Chemical composition, antioxidant and antimicrobial activities of essential oils from leaves, aerial stems, basal stems, and rhizomes of Etlingera fimbriobracteata (K.Schum.) R.M.Sm. Ind. Crops Prod. 2016, 84, 189–198. [Google Scholar] [CrossRef]
Sample Availability: Samples of the compounds are available from the authors. |

| F. oxysporum | F. solani | C. destrutans | |
|---|---|---|---|
| A. tsao-ko | 5.37 | 55.42 | 109.27 |
| A. officinarum | 33.16 | 54.78 | 64.13 |
| Hymexazol | 25.63 | 36.74 | 15.66 |
© 2018 by the authors. Licensee MDPI, Basel, Switzerland. This article is an open access article distributed under the terms and conditions of the Creative Commons Attribution (CC BY) license (http://creativecommons.org/licenses/by/4.0/).
Share and Cite
Sun, W.-M.; Ma, Y.-N.; Yin, Y.-J.; Chen, C.-J.; Xu, F.-R.; Dong, X.; Cheng, Y.-X. Effects of Essential Oils from Zingiberaceae Plants on Root-Rot Disease of Panax notoginseng. Molecules 2018, 23, 1021. https://doi.org/10.3390/molecules23051021
Sun W-M, Ma Y-N, Yin Y-J, Chen C-J, Xu F-R, Dong X, Cheng Y-X. Effects of Essential Oils from Zingiberaceae Plants on Root-Rot Disease of Panax notoginseng. Molecules. 2018; 23(5):1021. https://doi.org/10.3390/molecules23051021
Chicago/Turabian StyleSun, Wu-Mei, Yu-Nan Ma, Yan-Jiao Yin, Chuan-Jiao Chen, Fu-Rong Xu, Xian Dong, and Yong-Xian Cheng. 2018. "Effects of Essential Oils from Zingiberaceae Plants on Root-Rot Disease of Panax notoginseng" Molecules 23, no. 5: 1021. https://doi.org/10.3390/molecules23051021
APA StyleSun, W.-M., Ma, Y.-N., Yin, Y.-J., Chen, C.-J., Xu, F.-R., Dong, X., & Cheng, Y.-X. (2018). Effects of Essential Oils from Zingiberaceae Plants on Root-Rot Disease of Panax notoginseng. Molecules, 23(5), 1021. https://doi.org/10.3390/molecules23051021
